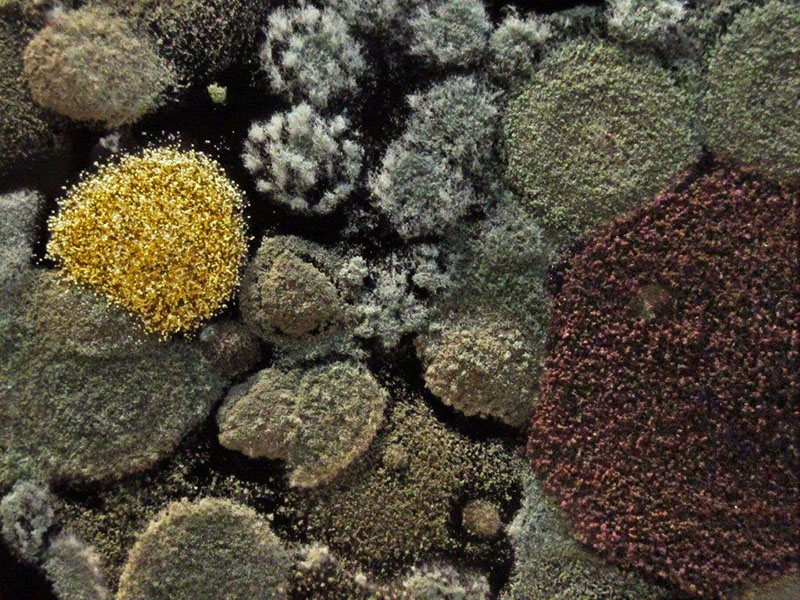
Mold on coffee

Juliet, Honey, and Nature’s Beauty – UPDATE March 12, 2014
 Juliet and male cubJuliet is an experienced mother and seems to take birthing and caring for cubs in stride. She has seldom vocalized to her cubs and her lack of vocalization during their birth made it difficult for us to determine the time of each birth. So when she quickly responded to a sharp cub cry at 3:47 AM today, we took note. She jumped up and began grunting and checking on the cubs. It was the most vocalization from her that we have heard to date.
Juliet and male cubJuliet is an experienced mother and seems to take birthing and caring for cubs in stride. She has seldom vocalized to her cubs and her lack of vocalization during their birth made it difficult for us to determine the time of each birth. So when she quickly responded to a sharp cub cry at 3:47 AM today, we took note. She jumped up and began grunting and checking on the cubs. It was the most vocalization from her that we have heard to date.
 Juliet playing with cubDen-watchers spotted a male cub again. No females yet. We don’t know if we’re seeing the same male over and over or if they’re all males.
Juliet playing with cubDen-watchers spotted a male cub again. No females yet. We don’t know if we’re seeing the same male over and over or if they’re all males.
Today, we saw Juliet play briefly with a cub in the typical "mouth over neck" fashion we have seen in years past. This could be the beginning of much more activity in the den. In past years, we watched Lily be very playful with her cubs and Jewel less so with hers. We wonder where Juliet will fall on the ‘play spectrum.’
 Honey soaks up the sunHoney is helping us explore a new idea. With the low electric fence turned off for the winter, she can climb over it and lounge near the viewing windows in the only snow-free area available.
Honey soaks up the sunHoney is helping us explore a new idea. With the low electric fence turned off for the winter, she can climb over it and lounge near the viewing windows in the only snow-free area available.  Honey licks windowWe’ve been toying with the idea of removing that stretch of fence so Ted, Honey, Lucky, and Holly can come closer to the viewers—or making the fence lower and much closer to the windows. We are imagining a child looking up at a bear a foot or two away and seeing the details of its brown eyes and pink tongue. Honey is giving us a preview.
Honey licks windowWe’ve been toying with the idea of removing that stretch of fence so Ted, Honey, Lucky, and Holly can come closer to the viewers—or making the fence lower and much closer to the windows. We are imagining a child looking up at a bear a foot or two away and seeing the details of its brown eyes and pink tongue. Honey is giving us a preview.
We saw a new bit of nature’s beauty today thanks to the coffee maker sitting unattended at the WRI the last few weeks. Mold on coffeeWho would have believed the beauty of mold on the last half inch of coffee? We know nothing about mold but have a new appreciation for its colorful patterns.
Mold on coffeeWho would have believed the beauty of mold on the last half inch of coffee? We know nothing about mold but have a new appreciation for its colorful patterns.
Crows returned to the northland with the warmth (51F) of a couple days ago (March 10, 10:33 AM at WRI). In our 16 years of recording, reappearances have averaged March 3 but have ranged from February 20 in 2002 to March 14 in 2001.
Thank you for all you do.
—Lynn Rogers and Sue Mansfield, Biologists, Wildlife Research Institute and North American Bear Center
All photos taken today unless otherwise noted.
